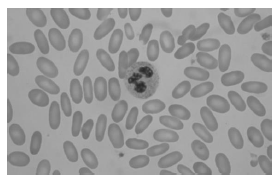
Enunciado 3476325-1

Foram encontradas 40 questões.
Sobre a Leucemia Promielocítica Aguda – M3, é correto afirmar que
Provas
Sobre as alterações morfológicas das hemácias, observa-se a presença de
Provas
Inclusões basofílicas, chamadas de pontilhados basófilos, podem ser vistas em pacientes portadores das seguintes condições, EXCETO,
Provas
Sobre os dacriócitos, é correto afirmar que
Provas

Na imagem acima, observa-se uma estrutura em forma de bastão no citoplasma destas células, chamadas de bastonetes de Auer. A presença dos bastonetes de Auer é patognomônico de leucemia
Provas
Na leitura do hemograma, é um índice que indica a anisocitose (variação de tamanho), sendo o normal de 11 a 14%, representando a percentagem de variação dos volumes obtidos.
O trecho refere-se ao
Provas
Hemácias espiculadas, com pontas pequenas; pode se tratar de artefato (problemas com o manejo da amostra coletada, por exemplo), uremia ou, raramente, eritroenzimopatia (deficiência de piruvato quinase).
O achado hematológico indicado pela descrição é
Provas
São exemplos de anemias microcíticas, EXCETO,
Provas
O diagnóstico de divertículo de Meckel está associado à perda de ferro por
Provas
Os corpúsculos de Howell-Jolly são inclusões basofílicas nas hemácias que ocorrem em estados de
Provas
Caderno Container